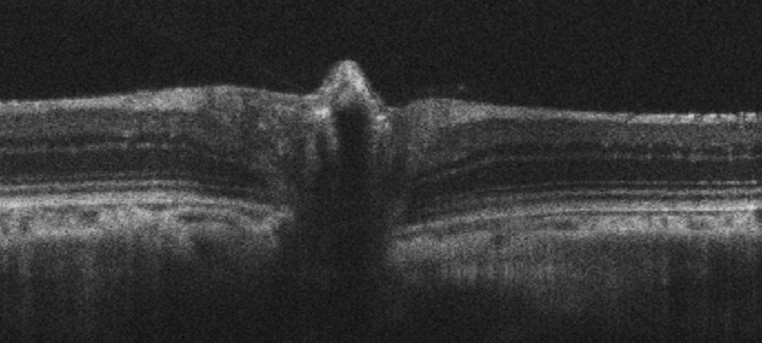
Noninvasive Assessment of the Visual System in Animal Models

CHIP has a wide range of equipment dedicated to cell, tissue, and stem cell culture from primary and immortalized cells; to imaging, real-time monitoring, long-term storing, and viral vectors preparation; and to the processing of cells for cellular and molecular biology applications. The histology resources include equipment for eye grossing, fixing, embedding, and sectioning fresh frozen, paraffin embedded, and glutaraldehyde fixed specimens. Eye tissue sections can be imaged using advanced imaging techniques, including light, fluorescence, confocal, and electron microscopy.
Recent additions to imaging equipment include:
- xCELLigence RTCA Real-Time Cell Analyzer (RTCA)
- EVOS Cell Imaging System
- Keyence BZ-X800 Microscope